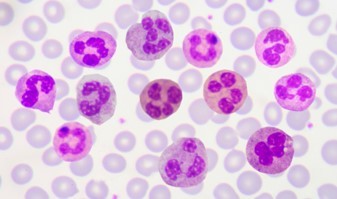

1
Q

A
Eosinophil
- Bilobed nucleus and have Charcot-Leyden crystals
- Battle infection (mostly helminths) and mediate allergic responses
Contain preformed mediators that are toxic to surround tissue and are released during cytolysis
- Major basic protein (MBP) – can be used to detect eosinophils
- Eosinophil cationic protein
- Eosinophil peroxididase
- Eosinophil-derived neurotoxin
2
Q

A
Basophil
- Least common circulating granulocyte
- Similar to mast cells
- Are important in late phase IgE mediated responses
- Mature in the bone marrow
- Found primarily circulating in blood (not tissue)
- Have CD123 (IL-3 receptor)
- IL-3 is important in their expansion / differentiation
- Unlike mast cells, basophils produce very little (or do not produce)
- Tryptase
- Chymase
- Carboxypeptidase
- Heparin
- PGD2
- LTB4
3
Q

A
Dendritic Cell
- Mononuclear cells with multiple projections
- Develop in response to IL-4
- Are the major APC
- Crucial in starting germinal centers
- Are immature in the tissue where the specialize in Ag uptake
- Mature in the lymphoid organs where the specialize in Ag presentation (increased MHCII expression)
- Express B7-1 & B7-2 (CD80/86) which interacts with CD28 on T-cells
4
Q

A
Macrophage
- Express CD14, CD11b/CD18 (Mac-1), and CD36
- Clear cellular debris
- Engulf bacterial invaders
- Present pathogens to T-helper cells via MCHII
- Activated by INFy & LPS
- INF-y made by Th and NK cells
Secrete cytokines
- TNFα
- IL-12
- IL-18
- IL-1
- IL-6
5
Q

A
Mast Cell
- Derived from stem cell factor Kit
- Kit+ (CD117+), CD34+
- Mature in the tissues (unlike basophils and eosinophils)
- Contain large cytoplasmic granules which are prefilled a with mediators (histamine)
- Mast cells and basophils contain the high affinity IgE receptor = FceRI
- FceRI = has one α-chain and β-chain each, as well as two y-chains
- IgE binds to mast cells via the α-chain of the FceRI rec
6
Q
A
- Neutrophils stain neutral (pink), and have multiple lobes of the nucleus
- Express surface rec for IgG and IgA
- IL-3, GM-CSF & GM-CSF are important in dev & prolif
- Circulate only for 4-10 hr (most of life in bone marrow)
Migrate to tissues via:
- IL-8 (CXCL-9)
- IFN-y
- F-met-leu-phe (fMLP) (bacterial protein that recruits to site of infection)
- LTB4
- Activated by Th17 cell cytokines
- Primary fxn is as phagocyte and killer
- Secrete cytokines
7
Q

A
Monocyte
- Are precursors to macrophages and dendritic cells
- Migrate to peripheral tissues and become a macrophage or dendritic cell
- Have surface rec for IgG, IgA, IgE
- Act as phagocytes and APC
- Express CD14 & CD16
- CD14 highly expressed by monocytes and macrophages
- CD14 binds LPS à activates TLR4
8
Q

A

9
Q
A
10
Q
What are the cell surface marker(s) for Basophils?
A
- Have CD123 (IL-3 receptor)
- IL-3 is important in their expansion / differentiation
11
Q
What are the cell surface marker(s) for Macrophages?
A
Express:
- CD14
- CD11b/CD18 (Mac-1)
- CD36
- Activated by INFy & LPS
- INF-y made by Th and NK cells
12
Q
What are the cell surface marker(s) for Neutrophils?
A
Express surface receptors for:
- IgG and IgA
- Activated by Th17 cell cytokines
- IL-3, GM-CSF & GM-CSF are important in dev & prolif
Migrate to tissues via:
- IL-8 (CXCL-9)
- IFN-y
- F-met-leu-phe (fMLP) (bacterial protein that recruits to site of infection)
- LTB4
13
Q
What are the cell surface marker(s) for Dendritic cells?
A
•Express B7-1 & B7-2 (CD80/86) which interacts with CD28 on T-cells
14
Q
What are the cell surface marker(s) for mast cells?
A
- Mast cells and basophils contain the high affinity IgE receptor = FceRI
- FceRI = has one α-chain and β-chain each, as well as two y-chains
- Derived from stem cell factor Kit
- Kit+ (CD117+), CD34+
- Mature in the tissues (unlike basophils and eosinophils)
15
Q
What are the cell surface marker(s) for monocytes?
A
- Express CD14 & CD16
- CD14 highly expressed by monocytes and macrophages
- CD14 binds LPS → activates TLR4
•Have surface rec for IgG, IgA, IgE


